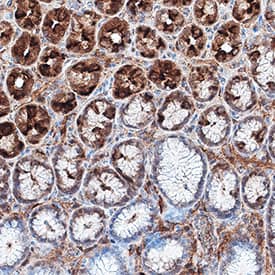
RTTN antibody in Human Stomach by Immunohistochemistry (IHC-P).

Human RTTN Antibody
R&D Systems, part of Bio-Techne | Catalog # MAB9966


Key Product Details
Species Reactivity
Applications
Label
Antibody Source
Product Specifications
Immunogen
Accession # Q86VV8
Specificity
Clonality
Host
Isotype
Scientific Data Images for Human RTTN Antibody
Detection of Human RTTN by Western Blot.
Western blot shows lysates of HeLa human cervical epithelial carcinoma cell line and Jurkat human acute T cell leukemia cell line. PVDF membrane was probed with 0.5 µg/mL of Rabbit Anti-Human RTTN Monoclonal Antibody (Catalog # MAB9966) followed by HRP-conjugated Anti-Rabbit IgG Secondary Antibody (Catalog # HAF008). A specific band was detected for RTTN at approximately 248 kDa (as indicated). This experiment was conducted under reducing conditions and using Immunoblot Buffer Group 1.RTTN in HDLM‑2 Human Cell Line.
RTTN was detected in immersion fixed HDLM-2 human Hodgkin's lymphoma cell line using Rabbit Anti-Human RTTN Monoclonal Antibody (Catalog # MAB9966) at 8 µg/mL for 3 hours at room temperature. Cells were stained using the NorthernLights™ 557-conjugated Anti-Rabbit IgG Secondary Antibody (red; Catalog # NL004) and counterstained with DAPI (blue). Specific staining was localized to cytoplasm. View our protocol for Fluorescent ICC Staining of Non-adherent Cells.RTTN in Human Stomach.
RTTN was detected in immersion fixed paraffin-embedded sections of human stomach using Rabbit Anti-Human RTTN Monoclonal Antibody (Catalog # MAB9966) at 1 µg/mL for 1 hour at room temperature followed by incubation with the Anti-Rabbit IgG VisUCyte™ HRP Polymer Antibody (Catalog # VC003). Tissue was stained using DAB (brown) and counterstained with hematoxylin (blue). Specific staining was localized to cytoplasm in gastric glands. View our protocol for IHC Staining with VisUCyte HRP Polymer Detection Reagents.Applications for Human RTTN Antibody
ELISA
This antibody functions as an ELISA detection antibody when paired with Mouse Anti-Human RTTN Monoclonal Antibody(Catalog # MAB99661).
This product is intended for assay development on various assay platforms requiring antibody pairs.
Immunocytochemistry
Sample: Immersion fixed HDLM-2 human Hodgkin's lymphoma cell line
Immunohistochemistry
Sample: Immersion fixed paraffin-embedded sections of human stomach
Western Blot
Sample: HeLa human cervical epithelial carcinoma cell line and Jurkat human acute T cell leukemia cell line
Reviewed Applications
Read 1 review rated 5 using MAB9966 in the following applications:
Formulation, Preparation, and Storage
Purification
Reconstitution
Formulation
Shipping
Stability & Storage
- 12 months from date of receipt, -20 to -70 °C, as supplied.
- 1 month, 2 to 8 °C under sterile conditions after opening.
- 6 months, -20 to -70 °C under sterile conditions after opening.
Background: RTTN
Human Rotatin, or RTTN, is a 2,226 amino acids (aa) protein discovered in a large-scale gene trap screen for factors that govern left-right specification. RTTN plays a role in the maintenance of a normal ciliary structure and is required for correct asymmetric expression of NODAL, LEFTY and PITX2. In humans, RTTN mutations link aberrant ciliary function to abnormal development and organization of the cortex and might be a cause of Primary Microcephaly, Primordial Dwarfism and other brain malformations.
Long Name
Alternate Names
Gene Symbol
UniProt
Additional RTTN Products
Product Documents for Human RTTN Antibody
Product Specific Notices for Human RTTN Antibody
For research use only